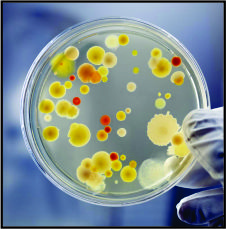
Mobirise Website Builder

Benefits
HumiBac Filters offers a wide range of benefits such as...
Ensures Food Safety
HumiBac Filters:
* reduces odours *
* less cross-contamination *
* less bacteria by up to 73% in 24 hours *

Fresher food lasting longer
HumiBac Filters
naturally balances humidity, absorbs up to 79% of ethylene gas and 92% of acetic acid in 24 hours.

Eco Friendly
HumiBac Filters
lowers the ambient temperature in a unit by eliminating air borne bacteria. The cooling unit uses up to 40% less energy.